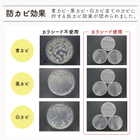
7-2.jpg

〜カラシのチカラでカビを防ぐ〜革製品・ホビー用品用の防カビ剤
20年以上にわたり選ばれ続けたカラシードシリーズから革製品・ホビー用品専用が誕生しました。 KARASEEDはカラシやワサビなどに含まれる成分を利用した防カビ剤です。 収納ケースに一緒に入れるだけで、高い防カビ効果を発揮します。 ワサビ・カラシ成分が持つ強い抗菌成分がカビに直接作用して「清潔な空間」をつくり皮革製品・ホビー用品をカビから守ります。 本格的なカビ対策なら「包材を選ばない」「カビに直接作用」するカラシードをご使用ください。 カラシードは包材の選定が必要なく、現在ご使用されている包材のままで使用できます。 また、最大の特徴は、ワサビ・カラシ成分が持つ強い抗菌成分がカビに直接作用することです。 最長6ヶ月効果が持続することもポイントです。
この製品へのお問い合わせ
基本情報
カラシのチカラでカビを防ぐカラシード カラシード(1包) サイズ:5×9cm/重量:約12g [ 成 分 ] アリルイソチオシアネート/ケイ酸塩
価格情報
お問い合わせください。 無償にてサンプルを提供しておりますので、お客様の商品でお試しください。
納期
用途/実績例
[使用対象] 保管時カビが発生しやすいもの ● 皮革製品 (バッグ・靴・グローブ・革小物など) ● ホビー用品(カメラレンズ・楽器・絵画道具・書道セットなど) [使用方法] ●収納ケース(目安:約10ℓ)に対して1個を入れてください。 ●革製品本体の中へ入れてください。 [交換目安] 約6カ月
詳細情報
-

自然派の防カビ剤
-

お気に入りをカビから守ります
-

本格的なカビ対策ならカビに直接作用するカラシードを
-

最長6ヶ月間、防カビ効果を発揮。輸出入にもおすすめです。
-

革靴の防カビ効果も一目瞭然!
-
青カビ・黒カビ・白カビ全てに防カビ効果が認められました。
-

使用方法も簡単。収納ケースに一緒に入れるだけで、高い防カビ効果を発揮します。
-

使用開始日も記入できます!
-

あらゆる収納におすすめです。
カタログ(1)
カタログをまとめてダウンロード企業情報
株式会社虎変堂は、わさびやカラシに含まれる成分アリルイソチオシアネート(AIT)を活用した抗菌・鮮度保持製品や植物性の消臭剤など、オリジナル製品の開発、製造を主として行っております。 期待以上の製品を作り、効果を正しく且つわかりやすく伝えるツール作りやデモンストレーション方法の提案、マーケティングに至るまで、社内外のチームの力を結集し今後益々加速をつけて行っていきたいと考えております。 お客様と共に企画し、試験と評価を繰り返し最終仕様を決定し世に送り出す業務(プライベートブランドやOEM製品)も毎年かなりの件数を重ねて参りました。 何かお役に立てることがございましたらお気軽にご相談ください。










